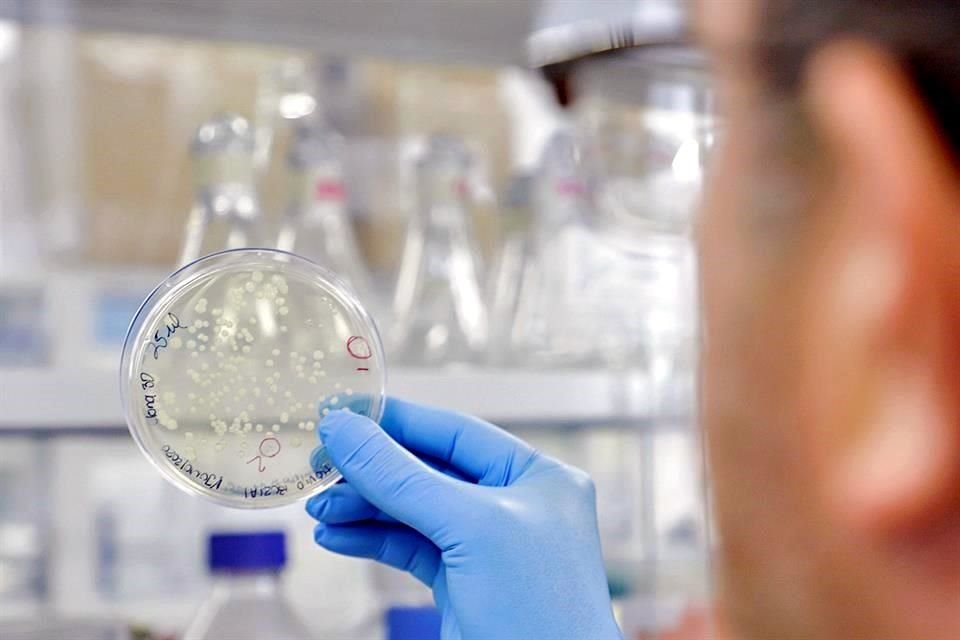
Sin mucho apoyo oficial, investigadores de la Universidad Autónoma de Querétaro trabajan desde hace un año en un proyecto contra SARS-CoV-2.

Vacuna con toque queretano
05 MIN 00 SEG
Israel Sánchez
Cd. de México (18 abril 2021) .-05:00 hrs

Sin mucho apoyo oficial, investigadores de la Universidad Autónoma de Querétaro trabajan desde hace un año en un proyecto contra SARS-CoV-2. Crédito: Cortesía UAQ
Sin mucho apoyo oficial, investigadores de la Universidad Autónoma de Querétaro trabajan desde hace un año en un proyecto contra SARS-CoV-2. Crédito: Cortesía UAQ
Sin mucho apoyo oficial, investigadores de la Universidad Autónoma de Querétaro trabajan desde hace un año en un proyecto contra SARS-CoV-2. Crédito: Cortesía UAQ
Dentro del ecosistema de proyectos vacunales contra el SARS-CoV-2 genuinamente gestados en el País, algunos avanzan con resultados prometedores a pesar de lidiar con el desinterés del Estado.